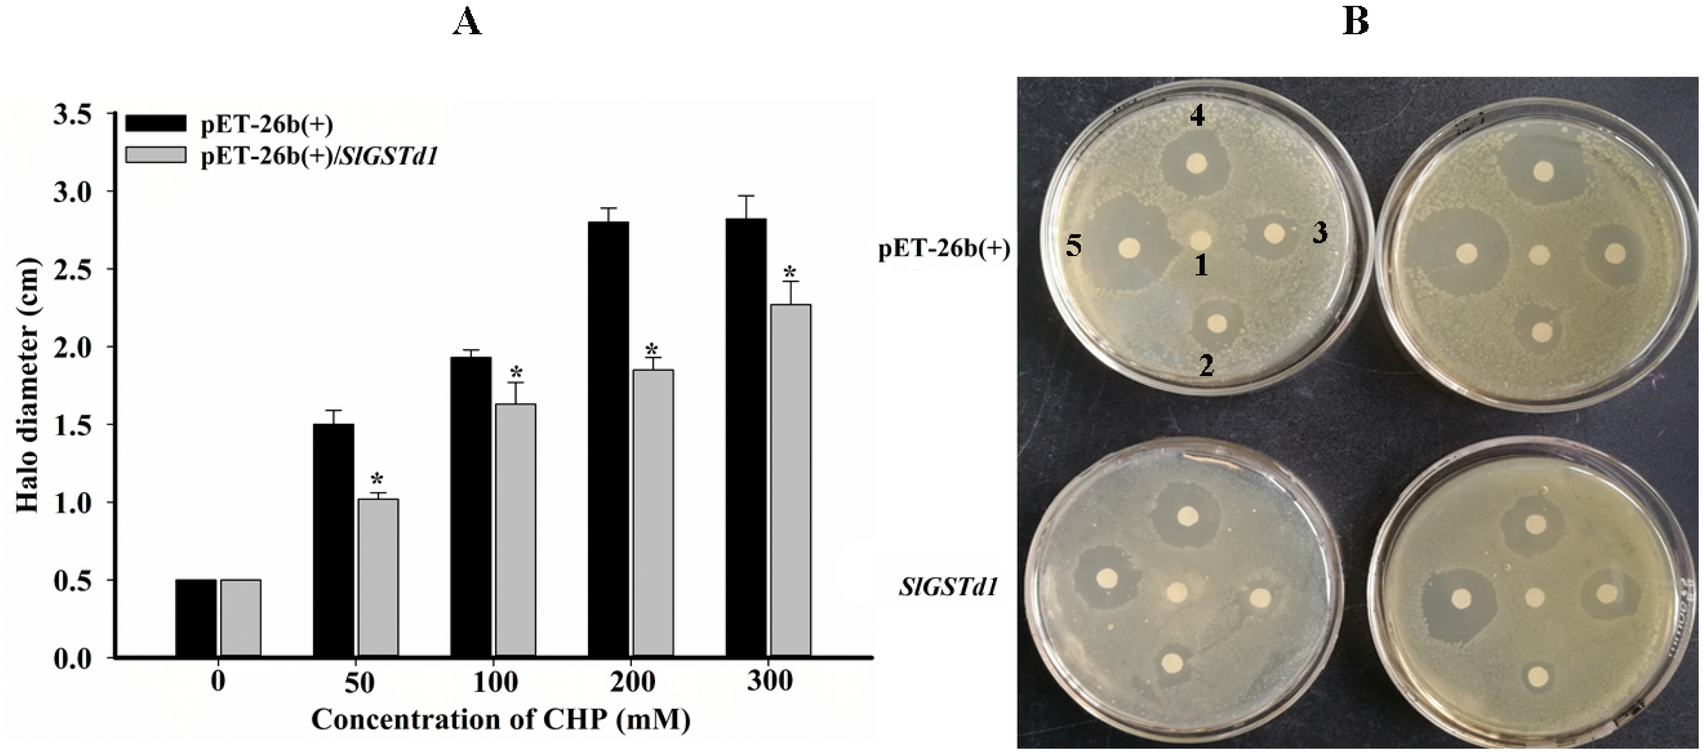
Figure 5

Figure 5
Inhibition zone halo diameter of E. coli expressing pET-26b(+)/SlGSTd1 and pET-26b(+) under different concentrations of CHP (A,B). (A) Error bar indicated SD of three replication. *Indicated significant differences between comparative groups (P < 0.05, student's t-test). (B) Labels 1–5: 0, 50, 100, 200, 300 mmol L−1.
